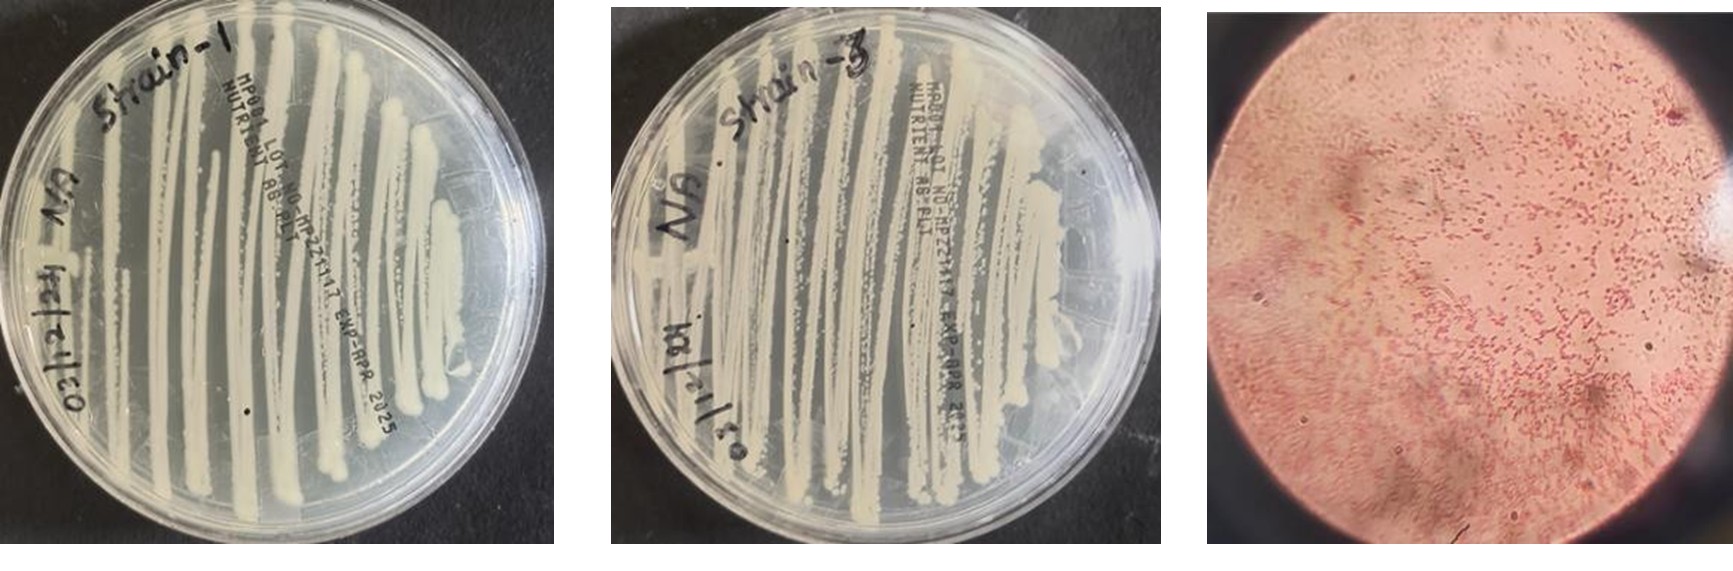
AI Health

Development of Biowrappers using Banana pseudo stem, Sugarcane bagasse and Arecanut husk
The project focuses on creating biodegradable wrappers for packaging from Banana pseudo stem, Sugarcane bagasse and Arecanut husk.
Read More
Full description: The project implements eco-friendly biowrappers using agricultural waste materials. Farmers gain additional income, waste is reduced, and sustainable packaging solutions are promoted. Materials are processed, molded into wrappers, and tested for durability and biodegradability.

Synthesis and Characterization of Eco-Friendly Bio Polymer from Musa paradisiaca Peel
Focuses on synthesis and characterization of an eco-friendly bio-polymer derived from banana peel.
Read More
Full description: Banana peels, rich in cellulose and starch, are processed to extract polysaccharides, polymerized into biodegradable polymers. Properties like strength and water resistance are enhanced. Characterization techniques like FTIR, UTM, and mechanical testing assess structure, thermal stability, and mechanical properties. Applications include sustainable packaging, agriculture, and biomedical fields.

Characterization and Value Added Textile Development from Areca catechu folium and Aloe vera
Fibers from Areca catechu folium and Aloe vera are processed and used to create eco-friendly textile products.
Read More
Full description: Fibers undergo chemical and enzymatic treatment, dried, tested for tensile strength and moisture retention. Yarns are produced through spinning and handloomed into eco-friendly bags, providing a sustainable alternative to synthetic materials.

Preparation of Areca Incense Sticks using Areca Husk
Using areca husk fibers to prepare low-cost, low-weight incense sticks with aromatic properties.
Read More
Full description: Areca nut husk fiber contains 53.2% cellulose, 32.98% hemicellulose, 7.2% lignin. Incense releases fragrant smoke when burnt. This project adds utility value to agricultural waste while producing eco-friendly incense.

Isolation and Characterization of Methanogen Bacteria for Higher Biogas Production
Methanogenic bacteria from cow dung and manure are isolated to optimize biogas production.
Read More
Full description: Pure strains are isolated using streaking and serial dilution. Metabolic properties are studied using biochemical tests, and strains identified via sequencing. This helps optimize biogas systems, promoting renewable energy and sustainability.

Formulation of Nourishing Hair Dye using Areca Catechu Peduncle Extract
Eco-friendly natural hair dye promotes strong and lustrous hair while reducing DHT production.
Read More
Full description: Areca husk rich in bioactive tannins blocks DHT synthesis, addressing androgenic alopecia. UV spectrometry ensures precise tannin measurement. The extract is formulated into herbal dye, combining coloring and therapeutic benefits.

Development of Hydrogel from Sugarcane Bagasse to Retain Soil Moisture
Hydrogel from sugarcane bagasse improves soil water retention and plant growth.
Read More
Full description: Cellulose from sugarcane bagasse is chemically cross-linked into hydrogel. This eco-friendly material absorbs water, reduces irrigation, enhances soil fertility, and repurposes agricultural waste.

Development of Biowrappers using Banana pseudo stem, Sugarcane bagasse and Arecanut husk
The project focuses on creating biodegradable wrappers for packaging from Banana pseudo stem, Sugarcane bagasse and Arecanut husk.
Read More
Full description: The project implements eco-friendly biowrappers using agricultural waste materials. Farmers gain additional income, waste is reduced, and sustainable packaging solutions are promoted. Materials are processed, molded into wrappers, and tested for durability and biodegradability.

Synthesis and Characterization of Eco-Friendly Bio Polymer from Musa paradisiaca Peel
Focuses on synthesis and characterization of an eco-friendly bio-polymer derived from banana peel.
Read More
Full description: Banana peels, rich in cellulose and starch, are processed to extract polysaccharides, polymerized into biodegradable polymers. Properties like strength and water resistance are enhanced. Characterization techniques like FTIR, UTM, and mechanical testing assess structure, thermal stability, and mechanical properties. Applications include sustainable packaging, agriculture, and biomedical fields.

Characterization and Value Added Textile Development from Areca catechu folium and Aloe vera
Fibers from Areca catechu folium and Aloe vera are processed and used to create eco-friendly textile products.
Read More
Full description: Fibers undergo chemical and enzymatic treatment, dried, tested for tensile strength and moisture retention. Yarns are produced through spinning and handloomed into eco-friendly bags, providing a sustainable alternative to synthetic materials.

Preparation of Areca Incense Sticks using Areca Husk
Using areca husk fibers to prepare low-cost, low-weight incense sticks with aromatic properties.
Read More
Full description: Areca nut husk fiber contains 53.2% cellulose, 32.98% hemicellulose, 7.2% lignin. Incense releases fragrant smoke when burnt. This project adds utility value to agricultural waste while producing eco-friendly incense.

Isolation and Characterization of Methanogen Bacteria for Higher Biogas Production
Methanogenic bacteria from cow dung and manure are isolated to optimize biogas production.
Read More
Full description: Pure strains are isolated using streaking and serial dilution. Metabolic properties are studied using biochemical tests, and strains identified via sequencing. This helps optimize biogas systems, promoting renewable energy and sustainability.

Formulation of Nourishing Hair Dye using Areca Catechu Peduncle Extract
Eco-friendly natural hair dye promotes strong and lustrous hair while reducing DHT production.
Read More
Full description: Areca husk rich in bioactive tannins blocks DHT synthesis, addressing androgenic alopecia. UV spectrometry ensures precise tannin measurement. The extract is formulated into herbal dye, combining coloring and therapeutic benefits.

Development of Hydrogel from Sugarcane Bagasse to Retain Soil Moisture
Hydrogel from sugarcane bagasse improves soil water retention and plant growth.
Read More
Full description: Cellulose from sugarcane bagasse is chemically cross-linked into hydrogel. This eco-friendly material absorbs water, reduces irrigation, enhances soil fertility, and repurposes agricultural waste.